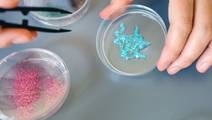
ReachMD Healthcare Image

advertisement
Health Technology
Articles 766-780 of 929
sciencedaily.com
07/24/2024
dicardiology.com
07/17/2024
uclahealth.org
07/17/2024
medicalxpress.com
07/17/2024
nyulangone.org
07/16/2024
phys.org
07/15/2024- advertisement
techxplore.com
07/11/2024
miragenews.com
07/11/2024
nih.gov
07/11/2024
neurolutions.com
07/10/2024
mdedge.com
07/05/2024
eurekalert.org
07/02/2024- advertisement
eecs.mit.edu
07/01/2024
tuni.fi
07/01/2024
miragenews.com
07/01/2024